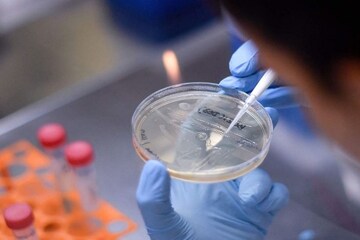
বাতাসে আর্দ্রতা কমে গেলে করোনা সংক্রমণ মারাত্মক হয়ে ওঠে, দাবি বিজ্ঞানীদের

বাতাসে আর্দ্রতা কমে গেলে করোনা সংক্রমণ মারাত্মক হয়ে ওঠে, দাবি বিজ্ঞানীদের
- Published by:Debalina Datta
- news18 bangla
Last Updated:
করোনা সংক্রমণ শীতকালে আরও মারাত্মক রোগ হবে
advertisement
1/5
দুনিয়া জুড়ে করোনা সংক্রমণ ব্যাপক হারে বৃদ্ধি পাচ্ছে ৷ আর এই মারণ ভাইরাস নিয়ে নিরন্তর রিসার্চ চালিয়ে যাচ্ছেন বৈজ্ঞানিকরা ৷ কিন্তু এখনও অবধি এই মারণ রোগের কোনও ভ্যাকসিন সামনে আসেনি ৷ এমনকি সঠিক কোন ওষুধের প্রয়োগে এই মারণ রোগের নিরাময় হবে তার রূপরেখাও পাওয়া যায়নি ৷ সিডনি বিশ্ববিদ্যালয় আর সাংহাই ফুডান ইউনিভার্সিটি অফ পাবলিক হেলথ একটি রিসার্চ চালিয়েছে ৷ তাদের বৈজ্ঞানিকরা দাবি করেছেন তাপমাত্রায় যখনই আর্দ্রতা কমে যায় তখনই এই ভাইরাস সংক্রমণের সম্ভবনা বহুগুণে বেড়ে যায় ৷ তাদের দাবি কোভিড ১৯ শীতকালের বড় রোগ হতে পারে ৷Photo- Representative
advertisement
2/5
সিডনিতে করোনা সংক্রমিত ৭৪৯ জনের ওপর পরীক্ষা করা হয়েছে ৷ এই রিসার্চে ২৬ ফেব্রুয়ারি তেকে ৩১ মার্চ অবধি এই রিসার্চ চলে ৷ যেখানে বৃষ্টি, আর্দ্রতা এবং জানুয়ারি থেকে মার্চের তাপমাত্রার পরিবর্তন নিয়ে পরীক্ষা করা হয়েছে ৷ মহামারী বিশেষজ্ঞরা তাপমাত্রা সংক্রমণ এবং বাকি বিষয় নিয়ে পরীক্ষা করা হয়েছে ৷ যেখানে নানারকম মাপকাঠিতে এই পরীক্ষা হয়েছে ৷ ়যেখানে দেখা গেছে এই সংক্রমণে আর্দ্রতার মাপকাঠি একটা বড় ফ্যাক্টর ৷Photo- Representative
advertisement
3/5
সিডনি বিশ্ববিদ্যালয়ের প্রফেসার মাইকেল বার্ডের মত অনুযায়ী শীতের সময়ে কম আর্দ্রতা বড় ফ্যাক্টর হতে পারে ৷ আর্দ্রতা কমে যাওয়ার ফলে কণা হালকা হয়ে যায় আর ছোট হয়ে যায় ৷ এর জন্যে সংক্রমণ আরও বড় আকারের হয়ে যায় ৷ চিন , ইউরোপ, উত্তর আমেরিকার শীত থাকার ফলে ই এই অতিমারী এত বড় আকারের হয়ে গিয়েছিল ৷Photo- Representative
advertisement
4/5
রিসার্চাররা জানিয়েছে দাবি করেছেন, আর্দ্রতা কমে গেলে হাওয়া শুষ্ক হয়ে যায় ৷ ফলে কণা ছোট ও হালকা হয়ে যেতে থাকে ৷ ফলে লম্বা সময়ে বাতাসে নিজেকে টিকিয়ে রাখতে পারে ৷ এই সময়ে কেউ হাঁচলে বা কাশলে কণা বাতাসে অনেকক্ষণ টিকে থাকতে পারে ৷ যখন হাওয়ায় আর্দ্রতা বাড়ে তখন কণা বড় ও ভারী থাকে ফলে ভাইরাস কণা নীচে নেমে যায় ৷Photo- Representative
advertisement
5/5
মঙ্গলবারও সারা পৃথিবীতে করোনা সংক্রমণ ছড়িয়ে পড়ছে ৷ ১,১০,০০০ নতুন আক্রান্ত হয়েছে ৷ সারা পৃথিবীতে মোট সংক্রমিতের সংখ্যা ৬৪, ৭৪,০০০৷ ২৪ ঘণ্টায় মৃতের সংখ্যা ৪৫০০ ৷ আর মোট মৃতের সংখ্যা ৩,৮১,৭০০ ৷Photo- Representative
বাংলা খবর/ছবি/করোনা ভাইরাস/
বাতাসে আর্দ্রতা কমে গেলে করোনা সংক্রমণ মারাত্মক হয়ে ওঠে, দাবি বিজ্ঞানীদের